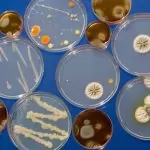

Contents
- 0.1 Conheça melhor o curso Básico de NR 1
- 0.2 A NR 1
- 0.3 A Norma Regulamentadora 1
- 0.4 Saúde e Segurança no Trabalho
- 0.5 A Gestão de Riscos
- 0.6 Observância Obrigatória
- 0.7 Ordem de Serviço de Segurança
- 0.8 O diálogo de Segurança
- 0.9 O Estudo dos Requisitos Básicos da NR 1
- 1 TOP 10 cursos online do site iEstudar
Conheça melhor o curso Básico de NR 1
Norma Regulamentadora 1 – NR 1 estabelece as disposições gerais, o campo de aplicação, os termos e as definições comuns às Normas Regulamentadoras – NR relativas à segurança e saúde no trabalho.
Matricule-s já! Aprenda sobre as responsabilidades do empregado e do empregador, estude sobre os termos e definições. Conheça mais sobre a NR 1 com o Curso Gratuito Online da iEstudar.
A NR 1
A NR 1 determina que as normas regulamentadoras, desde que possuam empregados regidos de acordo com a CLT, obrigatória para todas as empresas privadas e públicas, além dos órgãos públicos da administração direta e indireta, as diretrizes relativas à segurança e medicina do trabalho.
A Norma Regulamentadora 1
A iEstudar Cursos Online Gratuitos se preocupa com o aprendizado do aluno e planejou um bom material didático para estudos online para que possam conhecer a Norma Regulamentadora 1. A NR 1 introduz as demais NRs. Saiba mais.
A NR 1 é de fundamental importância para aplicação das demais normas regulamentadoras. A NR 1 estabelece as disposições gerais relativas à segurança e medicina do trabalho para todos os trabalhadores e empresas.
Saúde e Segurança no Trabalho
É a NR que estabelece disposições gerais e definições comuns às normas regulamentadoras de SST. Ela padroniza e harmoniza dispositivos e comandos para todas as normas, inclusive com a revogação de dispositivos previstos nas demais NR.
A Gestão de Riscos
Incorpora termos e definições associados à gestão de riscos, e estabelece tratamento diferenciado às micro e pequenas empresas. Estude grátis online. Estude sobre os requisitos da NR 1 com o Curso Livre online da iEstudar.
É de fundamental importância conhecer os direitos e deveres de empregadores e empregados em Segurança e Saúde do Trabalho.
Observância Obrigatória
São de observância obrigatória pelas organizações e pelos órgãos públicos da administração direta e indireta, bem como pelos órgãos dos Poderes Legislativo, Judiciário e Ministério Público, que possuam empregados regidos pela Consolidação das Leis do Trabalho (CLT).
Ordem de Serviço de Segurança
A iEstudar se preocupa com a saúde e integridade física de seus colaboradores, e buscou trazer este conhecimento para os nossos Cursos Livres Online. A educação é um direito de todos.
Conhece a exigência da “ordem de serviço de segurança e saúde no trabalho”? Ela está prevista na CLT (art. 157, II), no que se refere às instruções por escrito quanto às precauções para evitar acidentes do trabalho ou doenças ocupacionais.
O diálogo de Segurança
As informações podem ser transmitidas durante os treinamentos ou por meio de diálogos de segurança, documento físico ou eletrônico. A segurança no trabalho é um dever de todos. Estude sobre as NRs.
O Estudo dos Requisitos Básicos da NR 1
Com a facilidade de um ambiente virtual de aprendizagem que proporciona um aprendizado autoinstrucional é possível conhecer e estudar sobre todas as normas regulamentadoras. Estude agora! Não perca tempo. Aprenda já!
Conheça as Normas Regulamentadoras com os Cursos Online da iEstudar.
O conheicmento é a base.E este conhecimento poderá ser adquirido de forma online. Matricule-se já no Curso Básico de NR 1 da iEstudar! Boa leitura e bons estudos!
Certificado do curso online grátis Básico de NR 1
Um certificado de um curso livre pode ser válido para diversas finalidades, como por exemplo:
- Educação continuada
- Atividades complementares em faculdades
- Titularidade para professores
- Complementação de conhecimento
- Ascensão de carreira
- Contagem de carga horária
- Comprovação de Prova de Título
- Enriquecimento de currículo
- Concursos públicos
- Avaliações para promoções internas nas empresas
- Dentre outros…
TOP 10 cursos online do site iEstudar
Básico de NR 32
-> CURSO ONLINE GRÁTIS Básico de NR 32 com opção de certificado válido!
Básico de NR 23
-> CURSO ONLINE GRÁTIS Básico de NR 23 com opção de certificado válido!
Básico de NR 10
-> CURSO ONLINE GRÁTIS Básico de NR 10 com opção de certificado válido!
Básico de NR 7
-> CURSO ONLINE GRÁTIS Básico de NR 7 com opção de certificado válido!
Básico de NR 35
-> CURSO ONLINE GRÁTIS Básico de NR 35 com opção de certificado válido!
Básico de NR 33
-> CURSO ONLINE GRÁTIS Básico de NR 33 com opção de certificado válido!
Básico de NR 14
-> CURSO ONLINE GRÁTIS Básico de NR 14 com opção de certificado válido!
Básico de NR 29
-> CURSO ONLINE GRÁTIS Básico de NR 29 com opção de certificado válido!
Básico de NR 34
-> CURSO ONLINE GRÁTIS Básico de NR 34 com opção de certificado válido!
Básico de NR 18
-> CURSO ONLINE GRÁTIS Básico de NR 18 com opção de certificado válido!
Não perca mais tempo e venha estudar no iEstudar Cursos Online! Acesse aqui é totalmente grátis.